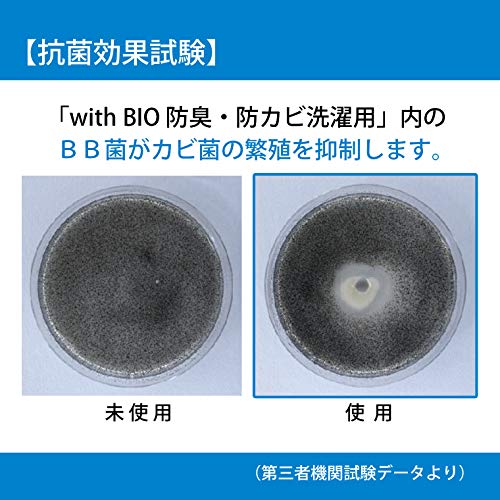
main

販売情報
画面をスクロールすると販売情報が更新されます。
最終更新:
最安値ショップ
最安値ショッピングサイト
実質価格ランキング
価格推移
| 日付 | amazon最安値 |
|---|---|
| 2025-12-08 | 10,560円 |
| 2022-07-10 | 1,345円 |
| 2022-07-10 | 1,359円 |
| 2022-07-03 | 1,345円 |
| 2022-07-02 | 1,359円 |
商品情報

商品サイズ (幅×奥行×高さ) :サイズ:約8.3×5.2×高さ20.5cm 原産国:日本 内容量:約500ml
| JANコード | 4540094413141 |
|---|---|
| 型番 | 413141 |
| メーカー | ビッグバイオ |
| ブランド | ビッグバイオ |






![[Set of 2] Machine Washable Lint Filter ES-LP1 ES-LP2 Compatible Scum Removal Net Lint Filter Washing Machine Dust Removal Ne](https://images-fe.ssl-images-amazon.com/images/I/61nfRKk8srL._AC_UL600_SR600,400_.jpg)


